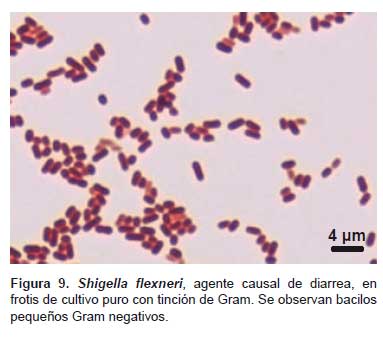

Servicios Personalizados
Revista
Articulo
Indicadores
-
 Citado por SciELO
Citado por SciELO
Links relacionados
-
 Similares en
SciELO
Similares en
SciELO
Compartir
Revista Peruana de Medicina Experimental y Salud Publica
versión impresa ISSN 1726-4634
Rev. perú. med. exp. salud publica v.28 n.1 Lima mar. 2011
GALERÍA FOTOGRÁFICA
Agentes etiológicos de diarea: bacterias y parásitos importantes en niños y adultos
Etiologic agents of diarhea: bacteria and parasites of importance in children and adults
Rito Zerpa L.1
1 Médico Patólogo Clínico, Servicio de Microbiología, Instituto Nacional de Salud del Niño, Instituto de Medicina Tropical Daniel A. Carrión, Universidad Nacional Mayor de San Marcos, Lima, Perú.
En las siguientes microfotografías se presenta bacterias y parásitos importantes (no se incluye algunas bacterias enteropatógenas ni virus) que son agentes etiológicos de diarrea en pacientes inmunocompetentes e inmunocomprometidos, niños y adultos, en especial de Vibrio cholerae, causante de la epidemia de cólera en el Perú y otros países en la década de 1990 y que en la actualidad afecta a países como Haití, El Salvador y Venezuela.
Las imágenes especiales, algunas a más de 1000 aumentos, bi- y tridimensionales, han sido obtenidas sin necesidad del microscopio electrónico de transmisión o de barrido (scanning); estos agentes etiológicos fueron hallados en muestras de pacientes con enfermedad diarreica, que acudieron para su atención al Instituto Nacional de Salud del Niño y al Instituto de Medicina Tropical Daniel A. Carrión (UNMSM).
Las imágenes pueden ser de utilidad para el diagnóstico microbiológico y parasitológico en el laboratorio clínico, en la docencia y en la investigación.

Correspondencia: Rito Zerpa Larrauri.
Correo electrónico: rzerpa43@yahoo.com














